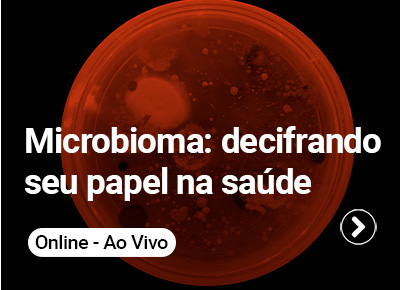

A Escola Superior do Instituto Butantan (ESIB) também promove o aprendizado coletivo e dinâmico por meio dos cursos online ao vivo. Diferente do formato EAD autoinstrucional, na modalidade online ao vivo você participa de aulas dinâmicas em tempo real, o que possibilita a interação com pesquisadores e palestrantes, além da oportunidade de tirar suas dúvidas durante a aula e interagir também com os demais participantes, promovendo assim um ambiente virtual colaborativo e engajador.
Oferecemos dezenas de cursos anualmente, cada um com carga horária e público-alvo específicos. As informações detalhadas e eventuais regras particulares podem ser consultadas na página de cada curso, disponível no catálogo abaixo. A seguir, explicamos as regras gerais de inscrição e seleção.
Oferecimento
Todos os cursos online ao vivo são realizados exclusivamente pela plataforma Zoom.
Como me inscrever?
Cada curso tem uma data específica para abertura de inscrições, indicada em sua sessão no catálogo.
- Para se inscrever, clique no link “INSCRIÇÕES”, disponível na página do curso de seu interesse.
- Você deverá preencher o formulário e concordar com os termos. Uma cópia das suas respostas será enviada para o e-mail cadastrado (verifique também a caixa de spam). Preencha o formulário com atenção e revise as informações antes do envio.
- Dias antes do oferecimento do curso, você receberá um e-mail contendo as informações necessárias para o acesso. O envio poderá ocorrer em prazos distintos, dependendo da necessidade de sorteio ou outro processo de seleção.
O período de inscrições é contínuo, ou seja, o formulário permanece aberto até a data de oferecimento do curso, exceto nas seguintes situações:
- Quando o número de inscritos de um curso excede o número de vagas - a ESIB fará um sorteio com todos os inscritos, e os contemplados serão comunicados por e-mail. A lista com os nomes também será publicada no site. Neste caso, o formulário de inscrição será fechado antecipadamente e a lista dos selecionados será divulgada em até cinco dias úteis antes da data de oferecimento do curso no site da ESIB na seção do curso correspondente.
- Quando um curso exigir o envio de documentação complementar (por exemplo, uma carta de intenção) - o formulário de inscrição será fechado antes para possibilitar a análise dos documentos enviados. Nesse caso, será divulgada uma lista de selecionados em até cinco dias úteis antes da data de oferecimento do curso no site da ESIB na seção do curso correspondente.
Certificação:
Após o término do curso, todos os participantes das aulas que fizeram sua inscrição e que obtiverem no mínimo 75% do tempo total de permanência - medido automaticamente pela plataforma - , receberão um link para avaliação do curso em até 10 dias úteis após o término do curso. Para alguns cursos também será considerada a entrega de atividades solicitadas pelos ministrantes.
⚠️Lembre-se de inserir seu nome completo corretamente ao realizar o cadastro, pois o certificado será emitido conforme as informações fornecidas.
⚠️ Os certificados emitidos, em regra, não garantem habilitação para o exercício de atividades profissionais regulamentadas que exigem formação técnica ou superior, nem são aceitos como títulos de pós-graduação lato sensu (especialização).
⚠️ ️ IMPORTANTE!
- Ao preencher nosso formulário de inscrição, você concorda, caso seja selecionado(a), com a divulgação de seu nome completo e os três primeiros dígitos do seu CPF em nosso site - mediante a necessidade de divulgação de lista de selecionados.
- Toda nossa comunicação com os inscritos é realizada via e-mail, portanto, verifiquem a caixa de Spam. Não entramos em contato via telefone.
A ESIB reserva-se ao direito de alterar ou cancelar os cursos oferecidos por motivos de força maior, comprometendo-se a comunicar todos os inscritos tão logo seja possível.
Em caso de dúvidas, escreva para: cursos.esib@butantan.gov.br
Próximos cursos
Inscrições encerradas
Modalidade: online ao vivo
Data do curso: 02 de março de 2026
Horário: 10h às 12h
Carga horária: 2h
Público-alvo: interessados no tema.
Local: plataforma Zoom
Valor: gratuito
Vagas: 1000
Escorpiões de Interesse em Saúde
Modalidade: online ao vivo
Data: 02 de março de 2026
Local: plataforma Zoom
Vagas: 1000
Público-alvo: interessados no tema.
Carga horária: 2h
Objetivo do curso: informar a população sobre os escorpiões.
Conteúdo: escorpiões: breves notas sobre a biologia, sinantropia, escorpionismo e vigilância epidemiológica; espécies de interesse em saúde no Brasil; procedimentos para coleta, transporte e destinação dos escorpiões; legislação; efeitos tóxicos de produtos empregados no combate dos escorpiões.
Responsável: Paulo André Margonari Goldoni
Inscrições encerradas
Modalidade: online ao vivo
Data do curso: 23 a 25 de março de 2026
Horário: 9h às 12h
Carga horária: 9h
Público-alvo: estudantes de graduação e pós-graduação em Ciências Biológicas e áreas afins; profissionais de coleções, museus, laboratórios e institutos de pesquisa.
Local: plataforma Zoom
Valor: gratuito
Vagas: 20
Introdução à sistemática filogenética: conceitos, métodos e aplicações práticas
Modalidade: online ao vivo
Data: 23 a 25 de março de 2026
Local: plataforma Zoom
Vagas: 20
Público-alvo: estudantes de graduação e pós-graduação em Ciências Biológicas e áreas afins; profissionais de coleções, museus, laboratórios e institutos de pesquisa.
Carga horária: 9h
Objetivo do curso: capacitar os participantes a compreender os fundamentos da sistemática filogenética, incluindo conceitos de homologia, caracteres, métodos de inferência, leitura e interpretação de árvores filogenéticas, proporcionando base para aplicação em pesquisa e comunicação científica.
Conteúdo: histórico e fundamentos teóricos da sistemática filogenética. Conceitos-chave: homologia, sinapomorfias, grupos monofiléticos. Princípios de codificação de caracteres morfológicos e moleculares. Métodos de inferência. Interpretação crítica de árvores filogenéticas e hipóteses evolutivas. Prática utilizando o programa TNT.
Responsável: Antonio Domingos Brescovit e Rodrigo Salvador Bouzan
Observação: ⚠️ para o curso será necessário instalar o software TNT (versão 1.6 - gratuito) https://www.lillo.org.ar/phylogeny/tnt/
Inscrições encerradas
Modalidade: online ao vivo
Data do curso: 10 de março de 2026
Horário: 9h às 13h
Carga horária: 4h
Público-alvo: bombeiros, policiais militares, policiais ambientais, agentes de saúde, prefeituras municipais, CCZs e profissionais que atuam em vigilância e controle dos escorpiões.
Local: plataforma Zoom
Valor: gratuito
Vagas: 1000
Controle de escorpiões de importância em Saúde
Modalidade: online ao vivo
Data: 10 de março de 2026
Local: plataforma Zoom
Vagas: 1000
Público-alvo: bombeiros, policiais militares, policiais ambientais, agentes de saúde, prefeituras municipais, CCZs e profissionais que atuam em vigilância e controle dos escorpiões.
Carga horária: 4h
Objetivo do curso: aprimorar o conhecimento dos profissionais de Saúde sobre a biologia dos escorpiões e a executar e orientar nas ações de captura e manejo em diferentes ambientes, com especial atenção à zona urbana.
Conteúdo: escorpiões: breves notas sobre a biologia, sinantropia, escorpionismo e vigilância epidemiológica; espécies de interesse em saúde no Brasil; procedimentos para coleta, transporte e destinação dos escorpiões; legislação; efeitos tóxicos de produtos empregados no combate dos escorpiões.
Responsável: Denise Maria Cândido e Alexandre Veloso Ribeiro
Inscrições encerradas
Modalidade: online ao vivo
Data do curso: 6, 8, 13, 15, 20, 22, 27 e 29 de abril (segundas e quartas) de 2026
Horário: 13h às 17h
Carga horária: 32h
Público-alvo: graduando, graduados ou pós-graduandos das diversas áreas do conhecimento.
Local: plataforma Zoom
Valor: gratuito
Vagas: 30
Análise espacial em Saúde: fundamentos e práticas com sistemas de informação geográfica
Modalidade: online ao vivo
Data: 6, 8, 13, 15, 20, 22, 27 e 29 de abril (segundas e quartas) de 2026
Local: plataforma Zoom
Vagas: 30
Público-alvo: graduando, graduados ou pós-graduandos das diversas áreas do conhecimento.
Carga horária: 32h
Objetivo do curso: capacitar os participantes no uso de Sistemas de Informação Geográfica (SIG) como ferramenta de apoio à análise espacial e à tomada de decisão em saúde, com ênfase em técnicas de georreferenciamento, elaboração de mapas temáticos e aplicação prática no software QGIS.
Conteúdo: introdução ao SIG e suas aplicações em saúde; ambiente e ferramentas do QGIS; georreferenciamento e construção de bases espaciais; elaboração de mapas temáticos e análise espacial em saúde; aplicações práticas e estudos de caso
Responsável: Camila Lorenz
Seleção: envio de documentação comprobatória de pertencimento ao público-alvo e carta de interesse (a carta deve indicar como este curso se encaixa em seus objetivos e como você pode se beneficiar com a participação). A divulgação será realizada no site da ESIB e os participantes receberão confirmação por e-mail.
Inscrições encerradas
Modalidade: online ao vivo
Data do curso: 4 a 8 de maio de 2026
Horário: 10h às 12h
Carga horária: 15h
Público-alvo: pesquisadores, pós-graduandos, graduandos e técnicos que trabalham com o modelo zebrafish e desejam desenvolver habilidades de divulgação científica.
Local: plataforma Zoom
Valor: gratuito
Vagas: 300
Do aquário ao público: estratégias de Divulgação Científica com zebrafish
Modalidade: online ao vivo
Data: 4 a 8 de maio de 2026
Local: plataforma Zoom
Vagas: 300
Público-alvo: pesquisadores, pós-graduandos, graduandos e técnicos que trabalham com o modelo zebrafish e desejam desenvolver habilidades de divulgação científica.
Carga horária: 15h
Objetivo do curso: capacitar os que utilizam o zebrafish como modelo experimental a comunicar suas pesquisas de forma clara, acessível e atrativa, fortalecendo o diálogo entre ciência e sociedade.
Conteúdo: fundamentos da divulgação científica; zebrafish como ferramenta de comunicação; estratégias e formatos de divulgação; comunicação oral e eventos públicos; planejamento e impacto; propostas de atividades práticas.
Responsável: Mônica Lopes Ferreira
Inscrições encerradas
Modalidade: online ao vivo
Data do curso: 8 de maio de 2026
Horário: 10h às 12h
Carga horária: 2h
Público-alvo: interessados no tema.
Local: plataforma Zoom
Valor: gratuito
Vagas: 1000
Aranhas de importância em Saúde
Modalidade: online ao vivo
Data: 8 de maio de 2026
Local: plataforma Zoom
Vagas: 1000
Público-alvo: interessados no tema.
Carga horária: 2h
Objetivo do curso: divulgação sobre aracnídeos peçonhentos: informar a população sobre quais espécies são perigosas, os riscos que oferecem e como prevenir acidentes.
Conteúdo: em breve
Responsável: Antonio Domingos Brescovit
Inscrições encerradas
Modalidade: online ao vivo
Data do curso: 12 a 18 de maio de 2026 (dias úteis)
Horário: 10h às 12h
Carga horária: 10h
Público-alvo: graduandos e graduados, docentes, pesquisadores e demias profissionais das áreas da Saúde, Biológicas e Biotecnologia.
Local: plataforma Zoom
Valor: gratuito
Vagas: 1000
Aplicações da tecnologia do DNA recombinante: do câncer à moda
Modalidade: online ao vivo
Data: 12 a 18 de maio de 2026 (dias úteis)
Local: plataforma Zoom
Vagas: 1000
Público-alvo: graduandos e graduados, docentes, pesquisadores e demias profissionais das áreas da Saúde, Biológicas e Biotecnologia.
Carga horária: 10h
Objetivo do curso: oferecer conhecimento sobre ferramentas de biologia molecular que podem ser aplicadas em diferentes áreas relacionadas à saúde, meio ambiente, produção de alimentos e indústria têxtil.
Conteúdo: conceitos básicos de biologia molecular: DNA, RNA e proteínas; extração de material genético; amplificação de genes; enzimas de restrição; clonagem; produção de proteínas; microrganismos geneticamente modificados e aplicações: -tratamento de câncer; produção de vacinas; meio ambiente: produção de alimentos; indústria têxtil: fibras e pigmento.
Responsável: Claudia Trigo Pedroso de Moraes
Inscrições encerradas
Modalidade: online ao vivo
Data do curso: 18 a 29 de maio de 2026
Horário: 9h às 11h
Carga horária: 20h
Público-alvo: graduados nas áreas de Ciências Biológicas e da Saúde ou graduandos que já tenham cursado a disciplina de imunologia.
Local: plataforma Zoom
Valor: gratuito
Vagas: 1000
Introdução à imunologia
Modalidade: online ao vivo
Data: 18 a 29 de maio de 2026
Local: plataforma Zoom
Vagas: 1000
Público-alvo: graduados nas áreas de Ciências Biológicas e da Saúde ou graduandos que já tenham cursado a disciplina de imunologia.
Carga horária: 20h
Objetivo do curso: revisar conceitos básicos de imunologia; apresentar métodos comumente utilizados em imunologia; fornecer os conceitos básicos de produção de soros e vacinas; discutir temas atuais em imunologia.
Conteúdo: conceitos básicos de imunologia; sistema imune: órgãos e células; imunidade inata e inflamação; imunidade humoral; imunidade celular; ELISA e Western Blot; citometria de fluxo; PCR aplicada à imunologia; soros e vacinas.
Responsável: Carla Cristina Squaiella Baptistão
Inscrições: clique aqui
Modalidade: online ao vivo
Data do curso: 25 a 28 de maio de 2026
Horário: 9h às 12h
Carga horária: 12h
Público-alvo: graduandos e graduados em ciências biológicas, biomédicas e biotecnologia, além de profissionais da Saúde.
Local: plataforma Zoom
Valor: gratuito
Vagas: 1000
Anticorpos monoclonais terapêuticos: da descoberta à caracterização
Modalidade: online ao vivo
Data: 25 a 28 de maio de 2026
Local: plataforma Zoom
Vagas: 1000
Público-alvo: graduandos e graduados em ciências biológicas, biomédicas e biotecnologia, além de profissionais da Saúde.
Carga horária: 12h
Objetivo do curso: apresentar o conhecimento científico no desenvolvimento de anticorpos monoclonais terapêuticos, com foco na jornada que vai da descoberta via in vitro display à caracterização final dos anticorpos terapêuticos.
Conteúdo: introdução aos anticorpos monoclonais; técnicas in vitro display de descoberta de anticorpos monoclonais; métodos analíticos para a caracterização dos anticorpos monoclonais.
Responsável: Lilian Rumi Tsuruta
Seleção: envio de documentação comprobatória de pertencimento ao público-alvo e carta de interesse (a carta deve indicar como este curso se encaixa em seus objetivos e como você pode se beneficiar com a participação). A divulgação será realizada no site da ESIB e os participantes receberão confirmação por e-mail.
Inscrições: clique aqui
Modalidade: online ao vivo
Data do curso: 1 de junho de 2026
Horário: 10h às 12h
Carga horária: 2h
Público-alvo: interessados no tema.
Local: plataforma Zoom
Valor: gratuito
Vagas: 1000
Escorpiões de interesse em Saúde
Modalidade: online ao vivo
Data: 1 de junho de 2026
Local: plataforma Zoom
Vagas: 1000
Público-alvo: interessados no tema.
Carga horária: 2h
Objetivo do curso: informar a população sobre os escorpiões.
Conteúdo: escorpiões: breves notas sobre a biologia, sinantropia, escorpionismo e vigilância epidemiológica; espécies de interesse em saúde no Brasil; procedimentos para coleta, transporte e destinação dos escorpiões; legislação; efeitos tóxicos de produtos empregados no combate dos escorpiões.
Responsável: Paulo André Margonari Goldoni
Inscrições: clique aqui
Modalidade: online ao vivo
Data do curso: 22 a 26 de junho de 2026
Horário: 13h às 15h
Carga horária: 10h
Público-alvo: estudantes de graduação, pós-graduação das áres Biológicas e da Sáude e profissionais da Saúde.
Local: plataforma Zoom
Valor: gratuito
Vagas: 1000
Epidemiologia das doenças infecciosas e imunopreveníveis
Modalidade: online ao vivo
Data: 22 a 26 de junho de 2026
Local: plataforma Zoom
Vagas: 1000
Público-alvo: estudantes de graduação, pós-graduação das áres Biológicas e da Sáude e profissionais da Saúde.
Carga horária: 10h
Objetivo do curso: oferecer informações sobre a epidemiologia e vigilância das doenças imunopreveníveis no Brasil.
Conteúdo: introdução a epidemiologia e vigilância das doenças imunopreveníveis no Brasil; fases de desenvolvimento de vacinas e seus respectivos estudos; importância da farmacovigilância; avaliação econômica e hesitação vacinal.
Responsável: Manuela de Almeida Roediger
Inscrições: clique aqui
Modalidade: online ao vivo
Data do curso: 15 a 19 de junho de 2026
Horário: 10h às 12h
Carga horária: 10h
Público-alvo: estudantes de graduação, pós-graduação, técnicos de laboratório e pesquisadores interessados no modelo experimental zebrafish (Danio rerio).
Local: plataforma Zoom
Valor: gratuito
Vagas: 300
Ensaios de toxicidade em zebrafish: abordagens experimentais e aplicações científicas
Modalidade: online ao vivo
Data: 15 a 19 de junho de 2026
Local: plataforma Zoom
Vagas: 300
Público-alvo: estudantes de graduação, pós-graduação, técnicos de laboratório e pesquisadores interessados no modelo experimental zebrafish (Danio rerio).
Carga horária: 10h
Objetivo do curso: capacitar pesquisadores na utilização do modelo zebrafish (Danio rerio) em ensaios de toxicidade, abordando desde a biologia básica até as metodologias avançadas e interpretação de dados em toxicologia experimental.
Conteúdo: aspectos fundamentais do modelo zebrafish: biologia e manejo; regulamentação e ética; aplicações em toxicologia; toxicidade (aguda, crônica, comportamental, molecular) e tipos de exposição; metodologias de testes de toxicidade: toxicidade aguda, teratogenia do desenvolvimento, toxicidade da reprodução, cardiotoxicidade, hepatotoxicidade, neurotoxicidade, toxicidade comportamental, toxicidade molecular e bioquímica.
Responsável: Monica Lopes Ferreira
Inscrições: clique aqui
Modalidade: online ao vivo
Data do curso: 10 a 11 de junho de 2026
Horário: 13h às 17h
Carga horária: 8h
Público-alvo: graduandos, graduados, técnicos e profissionais de Saúde.
Local: plataforma Zoom
Valor: gratuito
Vagas: 1000
Farmacovigilância de soros e vacinas
Modalidade: online ao vivo
Data: 10 a 11 de junho de 2026
Local: plataforma Zoom
Vagas: 1000
Público-alvo: graduandos, graduados, técnicos e profissionais de Saúde.
Carga horária: 8h
Objetivo do curso: apresentar as bases teóricas da Farmacovigilância e o Sistema de Farmacovigilância vigente no país.
Conteúdo: as bases da farmacovigilância; Sistema Nacional de Farmacovigilância; a farmacovigilância no Instituto Butantan; avaliação de causalidade; estudos de casos; mitos e verdades e a segurança das vacinas
Responsável: Vera Lúcia Gattás
Inscrições: clique aqui
Modalidade: online ao vivo
Data do curso: 22 a 26 de junho de 2026
Horário: 9h às 12h
Carga horária: 15h
Público-alvo: graduados e graduandos nas áreas da ciência.
Local: plataforma Zoom
Valor: gratuito
Vagas: 1000
Ácaros: desvendando o Invisível
Modalidade: online ao vivo
Data: 22 a 26 de junho de 2026
Local: plataforma Zoom
Vagas: 1000
Público-alvo: graduados e graduandos nas áreas da ciência.
Carga horária: 15h
Objetivo do curso: capacitar os participantes no reconhecimento, coleta, preservação e estudo taxonômico de ácaros, com ênfase em grupos negligenciados e de relevância agrícola, médica, veterinária e ambiental, promovendo o conhecimento da biodiversidade e a aplicação prática da acarologia em diferentes contextos científicos.
Conteúdo: introdução e técnicas de coleta, preservação e montagem; grupos de ácaros negligenciados: Opilioacarida e Holothyrida; taxonomia de biodiversidade de Argasidae e Ixodidae; ácaros Mesostigmata de importância agrícola e de solo; ácaros Mesostigmata de interesse médico e veterinário; ácaros Trombidiformes predadores e de interesse médico e veterinário; ácaros oribatídeos: taxonomia e biodiversidade; ácaros plumícolas; ácaros dos cereais, poeira, sarna e alergias.
Responsável: Ricardo Bassini Silva
Inscrições: clique aqui
Modalidade: online ao vivo
Data do curso: 22 a 26 de junho de 2026
Horário: 10h às 12h
Carga horária: 10h
Público-alvo: estudantes de graduação e pós-graduação vinculados a cursos da área de Ciências Biológicas e da Saúde e profissionais interessados na área.
Local: plataforma Zoom
Valor: gratuito
Vagas: 150
Microbioma: decifrando seu papel na Saúde
Modalidade: online ao vivo
Data: 22 a 26 de junho de 2026
Local: plataforma Zoom
Vagas: 150
Público-alvo: estudantes de graduação e pós-graduação vinculados a cursos da área de Ciências Biológicas e da Saúde e profissionais interessados na área.
Carga horária: 10h
Objetivo do curso: capacitar o aluno a compreender os conceitos fundamentais do microbioma e sua relação sistêmica com a saúde, com foco especial no Eixo Microbiota-Intestino-Cérebro e modelos experimentais animais. Justificar a importância de modelos animais na pesquisa do microbioma. Apresentar as vantagens e aplicações do Zebrafish como modelo experimental para esta área.
Conteúdo: fundamentos e importância do microbioma; eixo microbiota-intestino-cérebro; microbioma e o sistema nervoso entérico; disbiose e efeitos à saúde; estudos de disbiose em modelos animais; zebrafish como um modelo para estudo do microbioma; alteração da microbiota induzidas experimentalmente em zebrafish: linhagens axênicas e gnotobióticas, tratamentos experimentais (probióticos, prebióticos e simbióticos) e disbiose induzida (DSS, antibióticos, dieta).
Responsável: Geonildo Rodrigo Disner
Inscrições: 16 de junho de 2026
Modalidade: online ao vivo
Data do curso: 30 de junho de 2026
Horário: 9h às 16h
Carga horária: 4h
Público-alvo: alunos de graduação e pós-graduação em áreas das Ciências Biológicas e da Saúde.
Local: plataforma Zoom
Valor: gratuito
Vagas: 1000
BCG: o legado de uma vacina centenária e a era da biotecnologia
Modalidade: online ao vivo
Data: 30 de junho de 2026
Local: plataforma Zoom
Vagas: 1000
Público-alvo: alunos de graduação e pós-graduação em áreas das Ciências Biológicas e da Saúde.
Carga horária: 4h
Objetivo do curso: apresentar a trajetória científica da vacina BCG, abordando sua importância histórica no controle da tuberculose e sua evolução biotecnológica. O curso visa proporcionar uma compreensão integrada dos fundamentos imunológicos da BCG e os avanços recentes em vacinas recombinantes.
Conteúdo: origem e contexto histórico da vacina BCG; a era Pasteur e o desenvolvimento da BCG por Calmette e Guérin; resposta imune induzida pela BCG: introdução e fundamentos, impacto global da BCG e situação epidemiológica da tuberculose; limitações da BCG clássica e a necessidade de novas formulações vacinais; aspectos imunológicos da BCG; mecanismos de resposta imune induzida pela BCG; limitações e variabilidade entre cepas utilizadas mundialmente; papel da BCG em imunoterapia, estudos de imunomodulação e efeitos inespecíficos (câncer, diabetes, outros patógenos); avanços científicos e tecnológicos; conceitos e fundamentos de vacinas recombinantes; BCG como plataforma biotecnológica: aplicações e perspectivas; exemplos de vacinas BCG recombinantes em desenvolvimento; tecnologias emergentes: uso do sistema CRISPR/Cas na modificação da BCG.
Responsável: Alex Issamu Kanno e Izadora Dillis Faccin
Inscrições: 19 de junho de 2026
Modalidade: online ao vivo
Data do curso: 29 de junho a 03 de julho de 2026
Horário: 9h às 13h
Carga horária: 20h
Público-alvo: graduandos, graduados e profissionais que atuem nas áreas da saúde humana, animal e biotecnológica.
Local: plataforma Zoom
Valor: gratuito
Vagas: 1000
Conhecendo os carrapatos e ácaros: transmissão de patógenos e moléculas de interesse biotecnológico
Modalidade: online ao vivo
Data: 29 de junho a 03 de julho de 2026
Local: plataforma Zoom
Vagas: 1000
Público-alvo: graduandos, graduados e profissionais que atuem nas áreas da saúde humana, animal e biotecnológica.
Carga horária: 20h
Objetivo do curso: apresentar aos cursistas a importância e o papel dos carrapatos como vetores de agentes causadores de doenças, bem como demais temáticas relacionadas de importância médico-veterinária.
Conteúdo: espécies de carrapatos de importância-médico-veterinária; carrapatos e o seu papel como vetores de patógenos; epidemiologia das doenças transmitidas; profilaxia; função das moléculas dos carrapatos para driblar o sistema de defesa do hospedeiro; moléculas de importância farmacológica; biologia estrutural; observação de órgãos internos através das microscopias de transmissão, varredura e de luz; características do câncer e os efeitos biológicos de toxinas de carrapatos sobre células tumorais.
Responsável: Simone Michaela Simons
Inscrições: 29 de junho de 2026
Modalidade: online ao vivo
Data do curso: 13 a 17 de julho de 2026
Horário: 9h às 13h
Carga horária: 20h
Público-alvo: graduandos, graduados e profissionais da área ambiental.
Local: plataforma Zoom
Valor: gratuito
Vagas: 1000
Ecotoxicologia e indicadores ambientais
Modalidade: online ao vivo
Data: 13 a 17 de julho de 2026
Local: plataforma Zoom
Vagas: 1000
Público-alvo: graduandos, graduados e profissionais da área ambiental.
Carga horária: 20h
Objetivo do curso: introduzir conceitos fundamentais aplicados em ecotoxicologia e no monitoramento ambiental, apresentando os organismos e as principais técnicas aplicadas na sua utilização como bioindicadores de qualidade ambiental.
Conteúdo: introdução à ecotoxicologia; contexto histórico; diferenças entre efeitos tóxicos, teratogênicos, mutagênicos e carcinogênicos; potenciais compartimentos de contaminantes nos ecossistemas naturais; destino e comportamento de contaminantes ambientais nos ecossistemas e nos organismos (biodegradação, bioacumulação e biomagnificação); conceitos de biomarcadores e bioindicadores; métodos de avaliações ecotoxicológicas; noções práticas de ensaios ecotoxicológicos em laboratório e no campo; a educação ambiental no contexto da ecotoxicologia; normatização e legislação ambiental; a pesquisa científica e o mercado de trabalho no Brasil; perspectivas futuras.
Responsável: Lenita de Freitas Tallarico
Inscrições: 02 de julho de 2026
Modalidade: online ao vivo
Data do curso: 03 a 07 de agosto de 2026
Horário: 14h às 17h
Carga horária: 15h
Público-alvo: docentes dos Anos Iniciais e Finais do Ensino Fundamental (prioritariamente em Ciências e/ou em regência no ciclo interdisciplinar).
Local: plataforma Zoom
Valor: gratuito
Vagas: 100
Serpentes, biodiversidade e pensamento científico no Ensino Fundamental
Modalidade: online ao vivo
Data: 03 a 07 de agosto de 2026
Local: plataforma Zoom
Vagas: 100
Público-alvo: docentes dos Anos Iniciais e Finais do Ensino Fundamental (prioritariamente em Ciências e/ou em regência no ciclo interdisciplinar).
Carga horária: 15h
Objetivo do curso: ampliar a compreensão dos conceitos de evolução, biodiversidade e conservação articulando-os às outras disciplinas e estimular o exercício do pensamento científico em sala de aula e a busca de estratégias para essa finalidade.
Conteúdo: evolução e biodiversidade; caracterização e história natural das serpentes; estudo de caso: a jararaca; análise de material didático e proposta de uso; a percepção da ciência e sua importância na formação do estudante.
Responsável: Otávio Marques
Inscrições: 27 de julho de 2026
Modalidade: online ao vivo
Data do curso: 10 a 12 de agosto de 2026
Horário: 13h30 às 17h
Carga horária: 10h
Público-alvo: interessados no tema.
Local: plataforma Zoom
Valor: gratuito
Vagas: 1000
Conceitos e técnicas de microscopia para análises de tecidos e cultura de células
Modalidade: online ao vivo
Data: 10 a 12 de agosto de 2026
Local: plataforma Zoom
Vagas: 1000
Público-alvo: interessados no tema.
Carga horária: 10h
Objetivo do curso: apresentar conceitos básicos de microscopia e técnicas de preparação e análise de tecidos e cultura celulares.
Conteúdo: microscopia: histórico e conceitos; microscopia de luz; microscopia de fluorescência confocal de varredura a laser; microscopia de transmissão; microscopia de varredura; cultura celular: conceitos e técnicas preparação de amostras de células em cultura e tecidos para análise através dos diversos tipos de microscopia.
Responsável: Janice Onuki
Inscrições: 31 de julho de 2026
Modalidade: online ao vivo
Data do curso: 10 de agosto de 2026
Horário: 10h às 12h
Carga horária: 2h
Público-alvo: interessados no tema.
Local: plataforma Zoom
Valor: gratuito
Vagas: 1000
Aranhas de importância em Saúde
Modalidade: online ao vivo
Data: 10 de agosto de 2026
Local: plataforma Zoom
Vagas: 1000
Público-alvo: interessados no tema.
Carga horária: 2h
Objetivo do curso: divulgação sobre aracnídeos peçonhentos: informar a população sobre quais espécies são perigosas, os riscos que oferecem e como prevenir acidentes.
Conteúdo: em breve
Responsável: Antonio Domingos Brescovit
Inscrições: 03 de agosto de 2026
Modalidade: online ao vivo
Data do curso: 17 a 21 e 24 a 28 de agosto de 2026
Horário: 10h às 12h
Carga horária: 20h
Público-alvo: graduados e graduandos das áreas de Ciências Biológicas e da Saúde, bem como integrantes de sociedades de acolhimento a pacientes com doenças neurodegenerativas.
Local: plataforma Zoom
Valor: gratuito
Vagas: 1000
Novos insights em doenças neurodegenerativas
Modalidade: online ao vivo
Data: 17 a 21 e 24 a 28 de agosto de 2026
Local: plataforma Zoom
Vagas: 1000
Público-alvo: graduados e graduandos das áreas de Ciências Biológicas e da Saúde, bem como integrantes de sociedades de acolhimento a pacientes com doenças neurodegenerativas.
Carga horária: 15h
Objetivo do curso: trazer atualizações sobre a etiologia, os mecanismos e as perspectivas de tratamento inovadores das doenças neurodegenerativas.
Conteúdo: etiologia e epidemiologia das doenças neurodegenerativas, principalmente Doença de Huntington, Parkinson, Alzheimer, Esclerose Lateral Amniotrófica, Esclerose Múltipla e outras. Serão abordados aspectos celulares e moleculares dessas doenças, bem como possíveis tratamentos, incluindo produtos de terapia avançada (terapias gênicas e celulares) e uso de moléculas bioativas de venenos e toxinas de animais.
Responsável: Irina Kerkis
Inscrições: 10 de agosto de 2026
Modalidade: online ao vivo
Data do curso: 17 a 21 de agosto de 2026
Horário: 14h às 17h
Carga horária: 15h
Público-alvo: interessados no tema.
Local: plataforma Zoom
Valor: gratuito
Vagas: 1000
História de vida de anfíbios e serpentes
Modalidade: online ao vivo
Data: 17 a 21 de agosto de 2026
Local: plataforma Zoom
Vagas: 1000
Público-alvo: interessados no tema.
Carga horária: 15h
Objetivo do curso: introduzir os fundamentos da evolução e da biologia de anfíbios e serpentes, enfatizando a origem e o papel adaptativo dos sistemas de defesa passiva e ativa, em cada grupo, através dos diferentes meios de produção de toxinas.
Conteúdo: conceitos biológicos gerais; evolução dos vertebrados: anfíbios e répteis; evolução dos sistemas de defesa: passiva e a ativa; biologia e a produção de toxinas em anfíbios e répteis; mitos e folclore relacionados aos venenos e às peçonhas.
Responsável: Carlos Jared e Marta Maria Antoniazzi
Inscrições: 17 de agosto de 2026
Modalidade: online ao vivo
Data do curso: 01 de setembro de 2026
Horário: 10h às 12h
Carga horária: 2h
Público-alvo: interessados no tema.
Local: plataforma Zoom
Valor: gratuito
Vagas: 1000
Escorpiões de interesse em Saúde
Modalidade: online ao vivo
Data: 01 de setembro de 2026
Local: plataforma Zoom
Vagas: 1000
Público-alvo: interessados no tema.
Carga horária: 2h
Objetivo do curso: informar a população sobre os escorpiões.
Conteúdo: escorpiões: breves notas sobre a biologia, sinantropia, escorpionismo e vigilância epidemiológica; espécies de interesse em saúde no Brasil; procedimentos para coleta, transporte e destinação dos escorpiões; legislação; efeitos tóxicos de produtos empregados no combate dos escorpiões.
Responsável: Paulo André Margonari Goldoni
Inscrições: 01 de setembro de 2026
Modalidade: online ao vivo
Data do curso: 14 a 18 de setembro de 2026
Horário: 10h às 12h
Carga horária: 10h
Público-alvo: estudantes de graduação, pós-graduação, técnicos de laboratório e pesquisadores interessados na área.
Local: plataforma Zoom
Valor: gratuito
Vagas: 100
Zebrafish como modelo experimental em pesquisas genéticas e moleculares
Modalidade: online ao vivo
Data: 14 a 18 de setembro de 2026
Local: plataforma Zoom
Vagas: 100
Público-alvo: estudantes de graduação, pós-graduação, técnicos de laboratório e pesquisadores interessados na área.
Carga horária: 10h
Objetivo do curso: contextualizar a importância e vantagens do zebrafish no campo dos estudos genéticos e moleculares, dado o conhecimento acerca do seu genoma e apresentar ferramentas de pesquisa aplicada que possibilitam análises de função e regulação gênica e modelagem de doenças humanas.
Conteúdo: introdução do uso do zebrafish (Danio rerio) na pesquisa científica; 10 anos do sequenciamento do genoma de zebrafish; correlação genética entre o modelo zebrafish e humanos; "forward and reverse genetics” em zebrafish; zebrafish mutantes: estudos de ganho e perda de função; ferramentas de edição gênica: Morfolino e CRISPR/Cas9 (knockdown e knockout); ferramentas de análise da expressão gênica (microarrays e RNA-seq); aplicações contextualizadas de estudos genéticos aplicados ao zebrafish; perspectivas e avanços do zebrafish como modelo experimental alternativo.
Responsável: Carla Lima da Silva e Rodrigo Disner
Inscrições: 02 de setembro de 2026
Modalidade: online ao vivo
Data do curso: 08 de setembro de 2026
Horário: 14h às 16h
Carga horária: 2h
Público-alvo: interessados no tema.
Local: plataforma Zoom
Valor: gratuito
Vagas: 1000
Noções básicas sobre desenvolvimento de vacinas
Modalidade: online ao vivo
Data: 29 de setembro de 2026
Local: plataforma Zoom
Vagas: 1000
Público-alvo: interessados no tema.
Carga horária: 2h
Objetivo do curso: oferecer noções sobre as etapas e os principais métodos para o desenvolvimento de novas vacinas.
Conteúdo: invenção das vacinas; resistência à vacinação; efeitos da vacinação e erradicação de doenças; o que são e quais os tipos de vacinas; imunidade coletiva; etapas do desenvolvimento de novas vacinas; vacinologia reversa; bioprocessos para desenvolvimento de vacinas; formulação de vacinas; exemplos de processos desenvolvidos para novas vacinas.
Responsável: Viviane Maimoni Gonçalves
Inscrições: 09 de setembro de 2026
Modalidade: online ao vivo
Data do curso: 21 a 25 de setembro e 28 de setembro de 2026, exceto sábado e domingo
Horário: 15h às 17h
Carga horária: 12h
Público-alvo: graduandos e graduados em Ciências Biológicas, Bioquímica, Química e áreas correlatas.
Local: plataforma Zoom
Valor: gratuito
Vagas: 1000
Biofísica na biotecnologia: introdução a técnicas para análise e caracterização de proteínas recombinantes
Modalidade: online ao vivo
Data: 21 a 25 de setembro e 28 de setembro de 2026, exceto sábado e domingo
Local: plataforma Zoom
Vagas: 1000
Público-alvo: graduandos e graduados em Ciências Biológicas, Bioquímica, Química e áreas correlatas.
Carga horária: 12h
Objetivo do curso: apresentar os conceitos básicos de técnicas biofísicas selecionadas e suas aplicações na análise e caracterização de proteínas recombinantes.
Conteúdo: proteínas: composição, estrutura e características para uso em análises. Conceitos e aplicações de cromatografia de exclusão molecular (SEC), espalhamento de luz dinâmico (DLS), fluorescência intrínseca de triptofano, fluorimetria diferencial de varredura (DSF); dicroísmo celular. Estudos de caso.
Responsável: Melissa Regina Fessel
Inscrições: 14 de setembro de 2026
Modalidade: online ao vivo
Data do curso: 29 de setembro de 2026
Horário: 9h às 13h
Carga horária: 4h
Público-alvo: bombeiros, policiais militares, policiais ambientais, agentes de saúde, prefeituras municipais, CCZs e profissionais que atuam em vigilância e controle dos escorpiões.
Local: plataforma Zoom
Valor: gratuito
Vagas: 1000
Controle de escorpiões de importância em Saúde
Modalidade: online ao vivo
Data: 29 de setembro de 2026
Local: plataforma Zoom
Vagas: 1000
Público-alvo: bombeiros, policiais militares, policiais ambientais, agentes de saúde, prefeituras municipais, CCZs e profissionais que atuam em vigilância e controle dos escorpiões.
Carga horária: 4h
Objetivo do curso: aprimorar o conhecimento dos profissionais de Saúde sobre a biologia dos escorpiões e a executar e orientar nas ações de captura e manejo em diferentes ambientes, com especial atenção à zona urbana.
Conteúdo: escorpiões: breves notas sobre a biologia, sinantropia, escorpionismo e vigilância epidemiológica; espécies de interesse em saúde no Brasil; procedimentos para coleta, transporte e destinação dos escorpiões; legislação; efeitos tóxicos de produtos empregados no combate dos escorpiões.
Responsável: Denise Maria Cândido e Alexandre Veloso Ribeiro
Inscrições: 21 de setembro de 2026
Modalidade: online ao vivo
Data do curso: 06, 08, 13, 15, 20, 22, 27, 29 de outubro e 03, 05 de novembro de 2026
Horário: 14h às 16h
Carga horária: 20h
Público-alvo: coordenadores de centro de pesquisa, pesquisadores, farmacêuticos e outros profissionais que atuam em centros de pesquisa (data entry, regulatório, dentre outros);alunos de pós-graduação; monitores de pesquisa; coordenadores e gerentes de estudos clínicos com fins de registro.
Local: plataforma Zoom
Valor: gratuito
Vagas: 50
Qualidade para centros de pesquisa: abordagem baseada no ICH E6 (R3)
Modalidade: online ao vivo
Data: 06, 08, 13, 15, 20, 22, 27, 29 de outubro e 03, 05 de novembro de 2026
Local: plataforma Zoom
Vagas: 50
Público-alvo: coordenadores de centro de pesquisa, pesquisadores, farmacêuticos e outros profissionais que atuam em centros de pesquisa (data entry, regulatório, dentre outros);alunos de pós-graduação; monitores de pesquisa; coordenadores e gerentes de estudos clínicos com fins de registro.
Carga horária: 20h
Objetivo do curso: capacitar os profissionais que atuam na área de pesquisa clínica nos princípios de qualidade, baseando-se nos requisitos do ICH E6 (R3), a fim de garantir a segurança, bem-estar e direitos dos participantes, integridade dos dados dos estudos clínicos conduzidos e aplicação dos aprendizados nas atividades de rotina do centro de pesquisa.
Conteúdo: boas práticas de documentação e integridade de dados; Introdução à análise de risco; Validação de sistemas computadorizados; Como responder um plano de ação de auditoria ou inspeção; Desvios de protocolo x desvios BPC, além da parte prática com análise de cenários reais da rotina do centro de pesquisa e desafios comuns em auditorias e inspeções.
Responsável: Joyce Fernandes Coutinho
Inscrições: 07 de outubro de 2026
Modalidade: online ao vivo
Data do curso: 19 a 23 de outubro de 2026
Horário: 12h às 17h
Carga horária: 15h
Público-alvo: estudantes de graduação, pós-graduação e profissionais de ciência interessados em comunicar seus estudos e descobertas na forma de divulgação científica.
Local: plataforma Zoom
Valor: gratuito
Vagas: 300
Divulgação Científica: primeiros passos
Modalidade: online ao vivo
Data: 19 a 23 de outubro de 2026
Local: plataforma Zoom
Vagas: 300
Público-alvo: estudantes de graduação, pós-graduação e profissionais de ciência interessados em comunicar seus estudos e descobertas na forma de divulgação científica
Carga horária: 15h
Objetivo do curso: introduzir fundamentos, boas práticas e técnicas para comunicar ciência ao público não especializado.
Conteúdo: histórico e conceitos importantes da divulgação científica; divulgação científica, por que fazemos?; público-alvo, linguagem e narrativa; planejando ações de divulgação científica; jornalismo científico e fake news; como falar com o público de temas polêmicos de ciência; plataformas e formatos; avaliação, impacto e ética; atividades práticas.
Responsável: Monica Lopes Ferreira
Inscrições: 19 de outubro de 2026
Modalidade: online ao vivo
Data do curso: 30 de outubro; 06 e 13 de novembro de 2026
Horário: 14h às 17h
Carga horária: 9h
Público-alvo: profissionais, técnicos, graduandos e graduados das áreas biomédicas.
Local: plataforma Zoom
Valor: gratuito
Vagas: 1000
Hemostasia - noções básicas
Modalidade: online ao vivo
Data: 30 de outubro; 06 e 13 de novembro de 2026
Local: plataforma Zoom
Vagas: 1000
Público-alvo: profissionais, técnicos, graduandos e graduados das áreas biomédicas.
Carga horária: 9h
Objetivo do curso: oferecer noções básicas sobre a hemostasia em condições fisiológicas.
Conteúdo: fisiologia da Hemostasia – noções gerais e básica; plaquetas sanguíneas – morfologia e função; coagulação sanguínea – bioquímica das proteínas e função; fibrinólise – bioquímica de proteínas e função; inibidores plasmáticos; vasos sanguíneos e endotélio vascular; noções sobre hemorreologia; testes de rotina laboratorial para a avaliação da hemostasia.
Responsável: Marcelo Larami Santoro
Inscrições: 26 de outubro de 2026
Modalidade: online ao vivo
Data do curso: 9 de novembro de 2026
Horário: 10h às 12h
Carga horária: 2h
Público-alvo: interessados no tema.
Local: plataforma Zoom
Valor: gratuito
Vagas: 1000
Escorpiões de interesse em Saúde
Modalidade: online ao vivo
Data: 9 de novembro de 2026
Local: plataforma Zoom
Vagas: 1000
Público-alvo: interessados no tema
Carga horária: 2h
Objetivo do curso: Informar a população sobre os escorpiões.
Conteúdo: escorpiões: breves notas sobre a biologia, sinantropia, escorpionismo e vigilância epidemiológica; espécies de interesse em saúde no Brasil; procedimentos para coleta, transporte e destinação dos escorpiões; legislação; efeitos tóxicos de produtos empregados no combate dos escorpiões.
Responsável: Paulo André Margonari Goldoni
Inscrições: 30 de outubro de 2026
Modalidade: online ao vivo
Data do curso: 10 de novembro de 2026
Horário: 10h às 12h
Carga horária: 2h
Público-alvo: interessados no tema.
Local: plataforma Zoom
Valor: gratuito
Vagas: 1000
Aranhas de importância em Saúde
Modalidade: online ao vivo
Data: 10 de novembro de 2026
Local: plataforma Zoom
Vagas: 1000
Público-alvo: interessados no tema
Carga horária: 2h
Objetivo do curso: divulgação sobre aracnídeos peçonhentos: informar a população sobre quais espécies são perigosas, os riscos que oferecem e como prevenir acidentes.
Conteúdo: em breve
Responsável: Antonio Domingos Brescovit
Inscrições: 05 de novembro de 2026
Modalidade: online ao vivo
Data do curso: 12 e 13 de novembro de 2026
Horário: 13h às 17h30
Carga horária: 8h
Público-alvo: interessados no tema.
Local: plataforma Zoom
Valor: gratuito
Vagas: 1000
Vamos falar de evolução
Modalidade: online ao vivo
Data: 12 e 13 de novembro de 2026
Local: plataforma Zoom
Vagas: 1000
Público-alvo: interessados no tema.
Carga horária: 8h
Objetivo do curso: fornecer informações para compreensão do desenvolvimento do pensamento evolucionista através da perspectiva da História da Ciência, desde a antiguidade aos dias atuais.
Conteúdo: Charles Darwin e a Teoria da Evolução através da Seleção Natural; a visão da Teoria da Evolução dos seres vivos desde a antiguidade até a atualidade.
Responsável: Carlos Jared
Inscrições: 09 de novembro de 2026
Modalidade: online ao vivo
Data do curso: 24 de novembro de 2026
Horário: 9h às 17h
Carga horária: 8h
Público-alvo: graduandos, graduados e profissionais das áreas de biologia, ambiental e veterinária que atuam em vigilância e controle dos escorpiões.
Local: plataforma Zoom
Valor: gratuito
Vagas: 1000
Escorpiões como um problema de Saúde Pública
Modalidade: online ao vivo
Data: 24 de novembro de 2026
Local: plataforma Zoom
Vagas: 1000
Público-alvo: graduandos, graduados e profissionais das áreas de biologia, ambiental e veterinária que atuam em vigilância e controle dos escorpiões.
Carga horária: 8h
Objetivo do curso: aprimorar o conhecimento dos profissionais sobre reconhecimento, importância epidemiológica e características biológicas dos escorpiões, com ênfase nas espécies de interesse para Saúde Pública.
Conteúdo: escorpionismo no Brasil; biologia dos escorpiões: história natural, morfologia, sistema sensorial, alimentação, reprodução; os escorpiões e o homem, espécies de interesse em Saúde no Brasil; controle, coleta, transporte e destinação dos escorpiões; legislação, criação e manutenção em cativeiro para obtenção de veneno e produção de soro; saúde veterinária dos escorpiões e efeitos tóxicos de produtos empregados no combate dos escorpiões.
Responsável: Denise Maria Candido e Thiago Mathias Chiariello
Inscrições encerradas
- Especialização
- Divulgação Científica
- Especialização Uma Só Saude
- Especialização Saúde
- Especialização em Biotérios
- Especialização em Farmacovigilância
- Programa da Ciência Butantan
- Validador